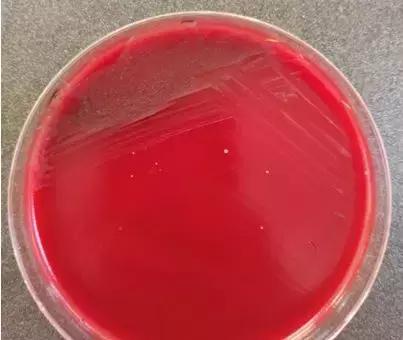
细菌感染血液检查结果,布鲁氏杆菌感染抽血检验

作者:李金刚,承德医学院附属医院南院区检验科
导引:
检验科临床微生物室提醒您:疾病千万种,发热第一种,原因不明确,医患两行泪。
眼下国产科幻电影“流浪地球”正在热映,炫酷的场景,感人的画面,不断地促使这部电影向着国产电影票房的第一把交椅飞速前进,影片中人类为了躲避太阳的膨胀,促使地球向外太空流浪,经历着千难万阻后终于………事实上,在某些疾病面前,为了寻找感染的病原,何尝不是如此艰辛,这让我想起了几个月前发生在我们医院的一例感染病例,千难万阻,我们终于找到了它………….
病程简介:
患儿,男,8岁
2018.8.7 体温突然39.2℃,无寒战、抽搐,当地医院诊断“急性上呼吸道感染”,蒲地兰治疗;
2018.8.11 右踝部肿胀,当地X线提示右踝骨皮质欠规整,外用膏药及口服药(具体不详);
2018.8.14以发热待查收入我院儿科,入院查体T37.6℃,抗链“O”918IU/ml,泌尿系B超提示:左侧输尿管囊肿 初步诊断:1、链球菌感染,2、左侧输尿管囊肿。头孢唑啉1.5g bid ivgtt;

2018.8.19 体温正常,感染指标正常,血培养回报无菌生长(常规培养5天)但脚踝还有轻微肿胀,儿外科会诊建议手术治疗输尿管囊肿;
入院治疗5天后,各项感染指标恢复正常,一切的一切都朝着我们预想的方向好转,眼下需要处理的好像只有输尿管囊肿这个坏人了,就像影片中地球马上就可以进入木星轨道,进而靠着木星的引力就可以脱离太阳系,飞向大宇宙了,我们接着往下看。
2018.8.23 转入儿外;
2018.8.30 手术;
2018.9.3 术后三天Tmax:39.3℃, PCT:0.52ng/ml, CRP:28.35mg/l;
WTF!!!发烧了又????术后应激反应?对,一定是!!等等,万一不是呢,明天叫个儿科会诊吧。
2018.9.4 术后四天Tmax:39.5℃,小儿内科会诊,考虑感染,抗生素升级为头孢哌酮舒巴坦;
啊啊啊!!!持续高热?先给他升个级,换个大炮来会会他。
2018.9.6 术后六天Tmax:39.8℃,手术切口愈合好,无渗出,发热考虑来自呼吸道,加用阿奇霉素;
2018.9.7 持续高热,送检血培养;
2018.9.8 术后8天 ,抗生素升级为美罗培南;
还是不行??怎么还是发烧??大炮看来也不行了,咱直接上导弹。
2018.9.10 血培养回报双侧短小杆菌生长,经鉴定后布鲁菌明确。同时虎红凝集试验结果阳性,抗体效价>1:400,请感染科会诊,布病诊断明确;

2018.9.11 转至感染科给予头孢曲松1g qd ivgtt;利福平45mg qd po;多西环素75mg q12 po;
2018.9.25 抗布病治疗后,病情稳定,脚踝肿胀消退,回家继续治疗,按时随访。
故事到这里接近尾声,让我先来介绍下我们的主人公-----布鲁氏菌!
布鲁菌为革兰阴性短小杆菌,具有至少6个种和19个生物型。多种家畜、家禽和野生动物是布鲁菌的宿主,与人类致病相关的主要有羊、牛、猪和犬。布鲁菌病是由布鲁菌引起的全身感染性疾病,以间歇性发热为主要症状,头、躯干及骨关节疼痛较为常见,也可表现为局部病灶组织器官受累,如肝、脾肿大,心悸,乏力,视力改变等 。布鲁菌病为动物源性,其传播途径有:(1)消化道,食用被病菌污染的奶、水、肉或动物内脏而感染;(2)皮肤黏膜,直接接触病畜或其排泄物,或在饲养、挤奶、剪毛、屠宰以及加工动物皮、毛、肉等过程中感染,也可因间接接触受病菌污染的环境及物品而感染;(3)呼吸道,通过吸入病菌污染的气溶胶而感染。人与人之间传播罕见,患者无需特殊隔离。但哺乳期妇女感染该菌后可由乳汁传至婴儿,或由器官移植供体传至受体,也存在通过性接触传播的可能。
布鲁菌是专性细胞内病原菌,一旦进入机体,能逃脱吞噬细胞的杀灭,并从细胞释放入血,随血液至相应组织器官,如骨髓、肝、脾、淋巴结、肺中形成肉芽肿或脓肿,布鲁菌还可引起心内膜炎、瓣膜病变以及中枢神经系统的感染,细菌反复多次入血可导致菌血症、败血症,内毒素是其主要致病物质。因此,布鲁菌病的临床表现形式多样,如发热、寒战、盗汗、头痛与体痛、乏力。也可引起骨、关节、心脏、肝、脾、肺,眼、皮肤软组织或中枢神经系统等脏器组织感染,并以这些部位为主要或首发临床表现。该病潜伏期通常是暴露后10~14 d,也可短至5 d或长达1年以上,呈急性或隐匿性。急性布鲁菌病,指患病在暴露后3个月以内。慢性布鲁菌病,指感染存在1年以上。对布鲁菌病的治疗应较长时间使用抗菌药物,如果随意终止治疗会使疾病复发。多样的临床表现增加了临床医生对布鲁菌感染做出早期、正确诊断的难度,也容易导致误诊。有报道临床有将布鲁菌病误诊为风湿病、结核病、腰椎病、淋巴瘤及系统性红斑狼疮等。
总结
让我们简单的总结下这个故事,几个叫布鲁的小家伙不知道通过什么途径进入了这个男性小可爱的身体里,他们闪转腾挪,一直流浪,有的顺着血管这条大河辗转于身体的某些部位,他们在各自的地盘繁衍生息,藏匿起来,他们混淆视听,善于伪装,躲过了第一次血培养的追捕,但是天网恢恢,第二次的海捕文书还是将它们一网打尽,无所遁形。这个故事无论是对医生,护士,还是微生物的工作人员都有一个很好地启示:首先,对于不明原因的发热一定要第一时间采集血培养,并且严格按指南要求采血:如血量足够、时机准确、消毒彻底;其次,沟通的重要性,对于原因不明的感染,采集标本后临床与实验室沟通,适当延长培养时间,避免遗漏掉生长缓慢的病原菌;最后,正确分析实验室检查结果,要综合运用检验的各种手段,来达到诊疗的目的。
这就是今天的流浪布鲁菌的小故事,大家一定要擦亮双眼,千万不可再让他有可乘之机!!!
(转自:检验视界网)